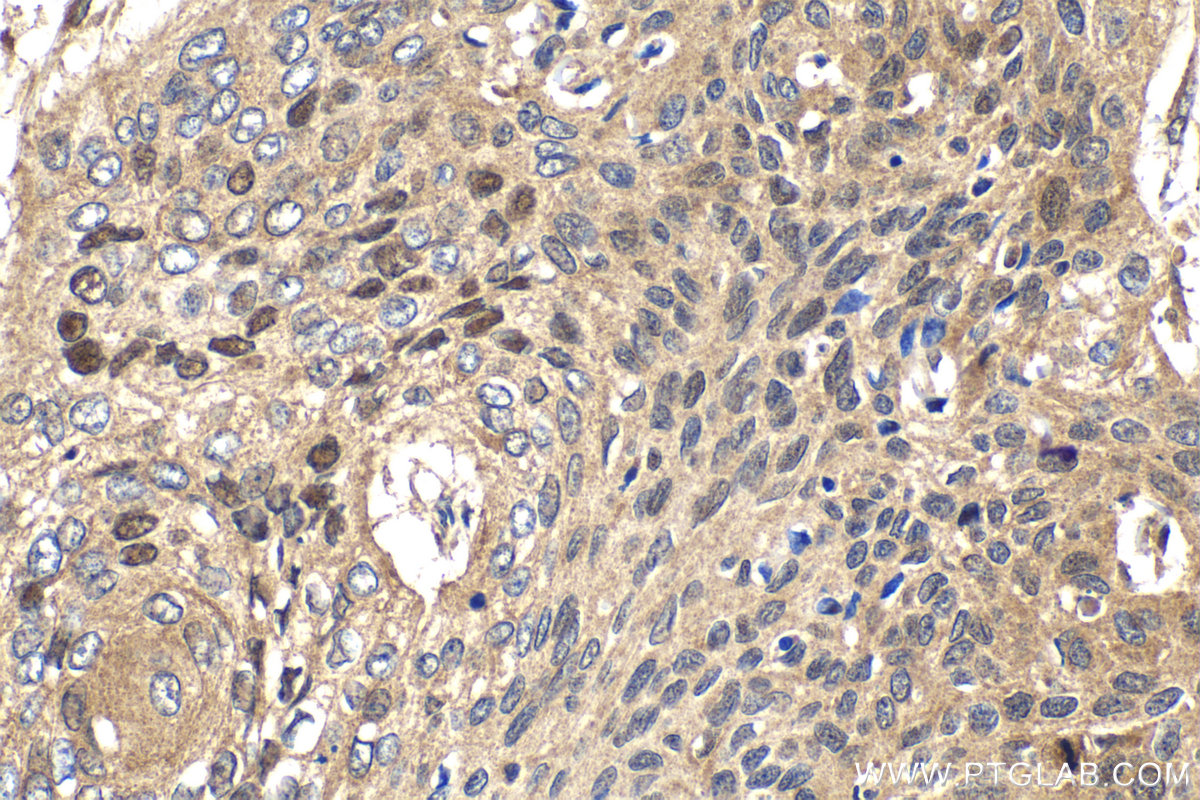

IHCeasy® PTTG1/Securin Ready-To-Use IHC Kit
PTTG1/Securin Ready-to-use reagent kit for IHC.
Reactivity
Human, Mouse, Rat
Sample Type
FFPE tissue
Cat no : KHC2152
Synonyms
PTTG1, Securin, PTTG, Pituitary tumor-transforming gene 1 protein, hPTTG
Validation Data Gallery
Product Information
KHC2152 is a ready-to-use IHC kit for staining of PTTG1/Securin. The kit provides all reagents, from antigen retrieval to cover slip mounting, that require little to no diluting or handling prior to use. Simply apply the reagents to your sample slide according to the protocol and you're steps away from obtaining high-quality IHC data.
| Product name | IHCeasy PTTG1/Securin Ready-To-Use IHC Kit |
| Sample type | FFPE tissue |
| Assay type | Immunohistochemistry |
| Primary antibody type | Rabbit Polyclonal |
| Secondary antibody type | Polymer-HRP-Goat anti-Rabbit |
| Reactivity | Human, Mouse, Rat |
Kit components
| Component | Size | Concentration |
|---|---|---|
| Antigen Retrieval Buffer | 100 mL | 50× |
| Washing Buffer | 100 mL ×2 | 20× |
| Blocking Buffer | 5 mL | RTU |
| Primary Antibody | 5 mL | RTU |
| Secondary Antibody | 5 mL | RTU |
| Chromogen Component A | 0.2 mL | RTU |
| Chromogen Component B | 4 mL | RTU |
| Signal Enhancer | 5 mL | RTU |
| Counter Staining Reagent | 5 mL | RTU |
| Mounting Media | 5 mL | RTU |
| Datasheet | 1 Copy | |
| Manual | 1 Copy |
Background Information
Securin, also known as the pituitary tumor transforming gene (PTTG1), was first isolated from rat pituitary tumor cells. Securin is a multi-functional protein that regulates sister chromatin segregation in mitosis, DNA repair, gene transcription, metabolism, and organ development. Securin is normally expressed in tissues with high proliferative activity, including the spleen, thymus gland, and testis, whereas it is rarely expressed in differentiated mature tissues.
Properties
| Storage Instructions | All the reagents are stored at 2-8°C. The kit is stable for 6 months from the date of receipt. |
| Synonyms | PTTG1, Securin, PTTG, Pituitary tumor-transforming gene 1 protein, hPTTG |